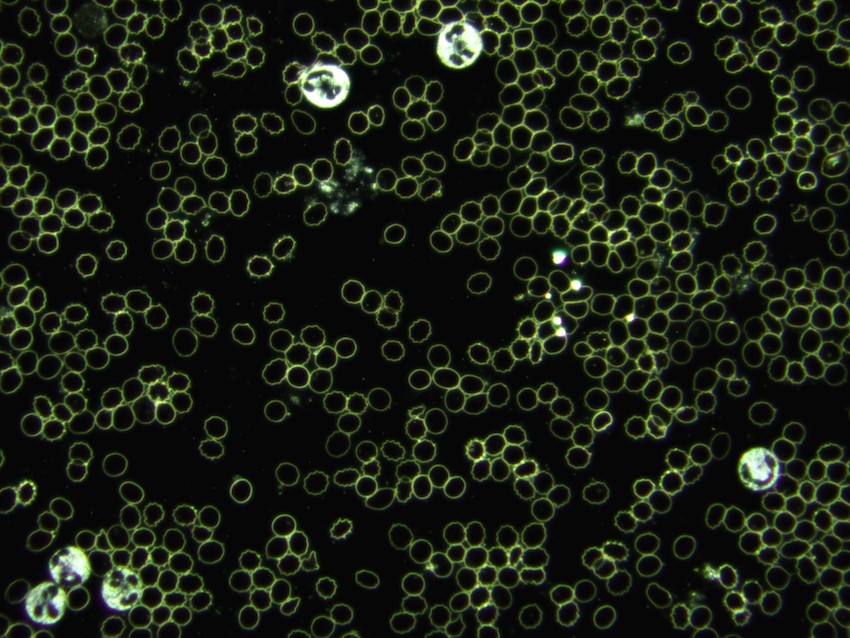

Untersuchungsmethoden
Irisdiagnostik
Bei der Betrachtung der Iris können wir anhand von Zeichen, Strukturen, Pigmenten und Farbverschiebungen diagnostische Hinweise bekommen.
Ohne große Hilfsmittel kann ein geübter Irisdiagnostiker Schwachstellen im gesamten Körper erkennen und entsprechende Therapieansätze empfehlen.
Dunkelfeld-Mikroskopie
Die Dunkelfeld-Mikroskopie ist eine spezielle Form der Blutuntersuchung, bei der lebendes Blut unter dem Mikroskop betrachtet wird.
Dabei werden die Blutzellen und ihre Umgebung in einem besonders kontrastreichen Licht sichtbar gemacht.
So können Veränderungen in Form, Beweglichkeit und Zusammenspiel der Zellen beobachtet werden.
Diese Beobachtungen können Hinweise auf innere Ungleichgewichte oder Belastungen geben, zum Beispiel bei:
- Störungen des Säure-Basen-Haushalts
- Anzeichen von oxidativem Stress (freie Radikale)
- Hinweise auf Durchblutungs- oder Stoffwechselstörungen
- Hinweise auf Immunschwäche oder chronische Belastungen
- Darm- und Verdauungsprobleme
- mögliche Belastungen durch Mikroorganismen (z. B. Bakterien, Pilze)
Die Dunkelfeldmikroskopie ersetzt keine schulmedizinische Diagnostik, kann aber wertvolle Informationen zur ganzheitlichen Beurteilung
der Vitalität liefern und die individuelle naturheilkundliche Therapie unterstützen.